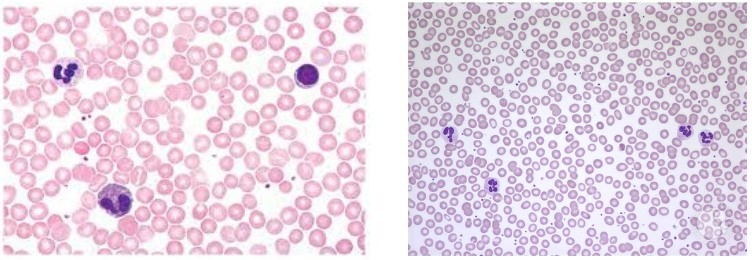

Non-keratinized stratified squamous ET
Multiple layers of cells; basal cells typically are cuboidal or polyhedral, whereas apical cells are squamous, surface cells are alive and kept moist.

Supportive CT
Hyaline Cartilage
Structure: glassy-appearing matrix; lacunae house condrocytes; usually covered by perichondrium
Function: smooth surface for movement at joints; model for bone growth; supports soft tissue
Location: covers articular ends of long bones; most of fetal skeleton; costal cartilage; most of the larynx, trachea, nose

Supportive CT
Compact Bone
Structure: calcified matrix arranged in osteons (concentric lamellae arranged around a central canal containing blood vessels
Function: supports soft structures; protects vital organs; provides levers for movement; stores calcium and phospherous
Location: Bones of the body

Simple squamous ET
Single layer of thin, flat, irregularly shaped cells resembling floor tiles; single nucleus of each cell bulges at center.

Supportive CT
Elastic Cartilage
Structure: contains abundant elastic fibers; elastic fibers form weblike mesh around lacunae; perichondrium present
Function: maintains structure and shape while permitting extensive flexibility
Location: external ear; epiglottis of larynx

Supportive CT
Fibrocartilage
Structure: readily visible; parallel collagen fibers in matrix; lacunae house condrocytes; no perichondrium
Function: resists compression; absorbs shock in some joints
Location: intervertebral discs; pubic symphysis; menisci of knee joints

Epithelial Tissue
Covers or lines every body surface and all body cavities.
Forms both external and internal lining of many organs, and constitutes the majority of glands.

Connective tissue proper
Dense regular CT
Structure: densely packed, parallel collagen fibers; fibroblast nuclei squeezed between layers of fibers; scarce ground substance
Function: attaches muscle to bone and bone to bone; resists stress applied in one direction
Location: tendons, mostly ligaments

Simple columnar ET
Single layer of columnar cells, attached to the basement membrane, with oval shaped nuclei located in the basal region.

Connective tissue proper
Reticular CT
Meshwork of reticular fibers.
Dark dots that resemble reticular cells and fibers are attached,
Structure: ground-substance is gel-like liquid; scattered arrangement of reticular fibers, fibroblasts, and leukocytes
Function: provides supportive framework for spleen, lymph nodes, thymus, bone marrow
Location: forms stroma of spleen, lymph nodes, thymus, bone marrow

Supportive CT
Spongy Bone
Structure: lacks the organization of compact bone; contains macroscopic spaces; bone arranged in a meshwork pattern
Function: Supports soft structures; protects vital organs; provides levers for movement; stores calcium and phosphorus. Spongy bone is the site of hemopoiesis.
Location: Bones of the body

Keratinized stratified squamous ET
Multiple layers of cells; basal cells typically are cuboidal or polyhedral, wheras apical (superficial) are squamous
Superficial cells are dead and filled with the protein keratin.

Connective Tissue
the “glue” that binds body structures together.
Connective tissue proper
Dense irregular CT
Structure: predominantly collagen fibers, randomly arranged and clumped together; fibroblasts in spaces among fibers;
Function: withstands stresses applied in all directions; durable
Location: Dermis; periosteum covering bone; perichondrium covering cartilage; organ capsules

Transitional ET
Epethial appearance varies; depending on whether tissue is stretched or relaxed; shape of cells at apical surface changes.
Some cells may be binucleated.

Connective tissue proper
Elastic CT
Structure: predominantly freely branching elastic fibers; fibroblasts occupy some spaces between fibers
Function: allows stretching of some organs
Location: walls of elastic arteries; trachea; bronchial tubes; true vocal cords; suspensory ligaments of penis

Connective tissue proper
Areolar CT
“small open spaces”; refers to appearance of small airy pockets between network of cells and fibers
has no obvious structure which is evident characteristic.
made of cells and extracellular matrix; fibers and ground substance
Structure: abundant vascularized ground substance is gel-like; scattered fibroblasts, many blood vessels
Function: surrounds and protects tissues and organs; loosely binds epithelia to deeper tissues; provides nerve and blood vessel packing
Location: papillary layer of dermis, subcutaneous layer under skin; surrounds organs

Ciliated pseudostratified columnar ET
Single layer of cells with varying heights that appear multilayered,all cells connect to the basement membrane, but not all cells reach the apical surface.
Has cilia and goblet cells.

Connective tissue proper
Adipose CT
Loose connective tissue that is primarily composed of adipocytes.
Resembles a sponge; hundreds of empty spaces where fat is stored in cells.
Structure: closely packed adipocytes; nucleus squeezed to one side by large fat droplet
Function: stores energy; protects, cushions, and insulates
Location: subcutaneous layer, covers and surrounds some layers

Blood
Structure: contains erythrocytes, leukocytes, and platelets; soluble protein fibers and a watery ground substance form a fluid extracellular matrix called plasma
Function: erythrocytes transport oxygen and some carbon dioxide. Leukocytes initiate and control immune response. Plasma contains clotting elements to stop blood loss. Platelets help with blood clotting. Plasma transports nutrients, wastes, and hormones throughout the body.
Location: primarily within blood vessels (arteries, veins, and capillaries) and the heart; leukocytes are also located in lymphatic organs and can migrate to infected or inflamed tissues in the body.
Simple cuboidal ET
Single layer of cells about as tall as they are wide; spherical, centrally located nucleus



